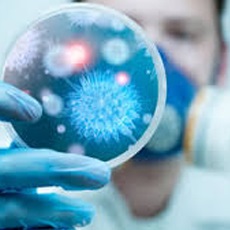

Control y seguimiento de padecimientos vasculares, manejo de pie diabetico, insuficiencia vascular periferica, trombosis arterial y venosa.

Estudio y tratamiento para el correcto funcionamiento del corazón y del aparato circulatorio tanto desde el punto de vista fisiológico como patológico.

Contamos con médicos especialistas que pueden atender problemas médico-quirúrgicos.

Prótesis de mama, botox (hilos rusos), lipectomías, cirugía funcional, y estética de naríz.

Diagnóstico y tratamiento de trastornos del sistema endocrino (diabetes, infertilidad, y problemas tiroideos, suprarrenales y de la hipófisis).

Contamos con un grupo de médicos certificados en el diagnóstico y tratamiento de las enfermedades que afectan el aparato digestivo (Ecografía, Endoscopia y Colonoscopia).

Atención prenatal, infertilidad, estirilidad, enfermedades de la mama, manejo del climaterio y tratamiento del cancer ginecologico.
Contamos con especialistas encargados del estudio, prevención, diagnóstico y tratamiento de las enfermedades producidas por agentes infecciosos (bacterias, virus, hongos y parásitos.

Contamos con especialistas capacitados para prevenir, diagnosticar y aplicar tratamientos no quirúrgicos en las patologías del adulto, incluyendo condiciones crónicas tales como enfermedades cardiacas.

Estudiamos la anatomía, patología, fisiología, prevención, terapia y rehabilitación de las enfermedades relacionadas con el aparato urinario, con una atención especial a los riñones.

El hospital cuenta con especialistas de gran prestigio, subespecialidades, infraestructura y áreas de soporte que permiten ofrecer al paciente una atención clínica de alta calidad.

Diagnostico y manejo de cualquier tipo de cancer.

Contamos con una clínica de columna vertebral para tratamiento de las hernias de disco con tratamiento "NO QUIRURGICO"

Manejo y tratamiento de pacientes con enfermedades y alteraciones del oído, nariz, garganta y estructuras relacionadas de la cabeza y del cuello.

Contamos con apoyo psicológico a cualquier edad que solicite

Control de crecimiento y desarrollo, neurologia pediatrica y cirugía pediatríca.

Contamos con un equipo de terapeutas altamente calificados para el tratamiento y rehabilitación de las lesiones o enfermedades que estén afectando tu calidad de vida.
